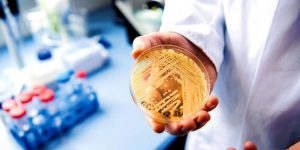

medicina
Estos son algunos de los consejos de los médicos para conciliar el sueño.
Céline Dion anunció la suspensión de sus shows justificando que se encontraba atravesando una dura enfermedad neurología. ¿Qué es y cuáles son las características del síndrome de la persona rígida?
Los profesionales de la salud piden que se respeten los pagos por dobles jornadas de guardia y por un aumento de sueldo.
El hongo es resistente a numerosos medicamentos y su mortalidad es del 39%, ganándose el nombre del superhongo.
La pareja que se encuentra en el proceso de investigación ya había participado en la creación de la vacuna Pfizer y BioNTech del Covid-19
Que puede ser de dos tipos, del tipo A y del B. Siendo el primero el que mayor circulación tuvo en la Argentina durante el 2022.
Se llevará a cabo un ensayo clinico en Mar del Plata para probar una novedosa medicación contra esta enfermedad, que puede causar un gran daño hepático.
La podrán consumir embarazadas, pacientes de cualquier edad y en cualquier etapa de la enfermedad. Si bien funciona en personas ya contagiadas tiene como objetivo no contagiar y poder vivir con normalidad.